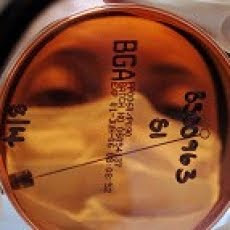

Posted by PuertoMadero in Uncategorized | 0 Comentarios
Preocupación por súperbacteria hospitalaria
11 de Agosto de 2010
Preocupación por súperbacteria hospitalaria
Científicos piden un esfuerzo internacional para combatir a una bacteria resistente a los antibióticos más poderosos.
.por BBC Mundo
Los investigadores creen que las súperbacterias que producen la enzima NDM-1 ya están bastante extendidas en la India y Pakistán, pero también se ha detectado su presencia en el Reino Unido, probablemente acarreada por personas que se sometieron a cirugías en esos países.
Otros casos también han sido reportados en Estados Unidos, Canadá, Australia y Holanda, lo que hace temer que pueda convertirse en un problema global.
Los científicos afirman en un artículo publicado en la revista The Lancet Infectious Diseases que, para evitar que ello ocurra, es necesaria mayor vigilancia internacional, así como el desarrollo de nuevos medicamentos.
En el sistema digestivo
El NDM-1 se encuentra por lo general en el sistema digestivo y puede existir dentro de otras bacterias, como la Escherichia coli, haciéndolas resistentes a los antibióticos más poderosos, conocidos como carbapenems.
Los científicos temen que pueda saltar a otras bacterias que ya son capaces de resistir a muchos otros antibióticos, lo que podría hacer cada vez más difícil el tratamiento de infecciones intrahospitalarias.
Para evitar que el NDM-1 se propague, dicen los investigadores, hay que identificar y aislar rápidamente a los pacientes infectados.
Medidas sencillas como desinfectar los equipos médicos y garantizar que médicos y enfermeras se laven las manos con jabón antibacteriano también ayudan.
Como explica la especialista en temas de salud de la BBC, Michelle Roberts, por el momento la mayoría de las bacterias que cargan al NDM-1 han podido ser tratadas usando una combinación de diferentes antibióticos.
El potencial para que el NDM-1 se convierta en endémico en el nivel mundial, sin embargo, “es claro y preocupante”, dice el artículo en la revista médica británica The Lancet.
El estudio fue llevado a cabo por la Universidad de Cardiff, en Gales, la Agencia de Protección Sanitaria del Reino Unido y varios colegas internacionales.
http://www.elmostrador.cl/vida-en-linea/2010/08/11/preocupacion-por-superbacteria-hospitalaria/